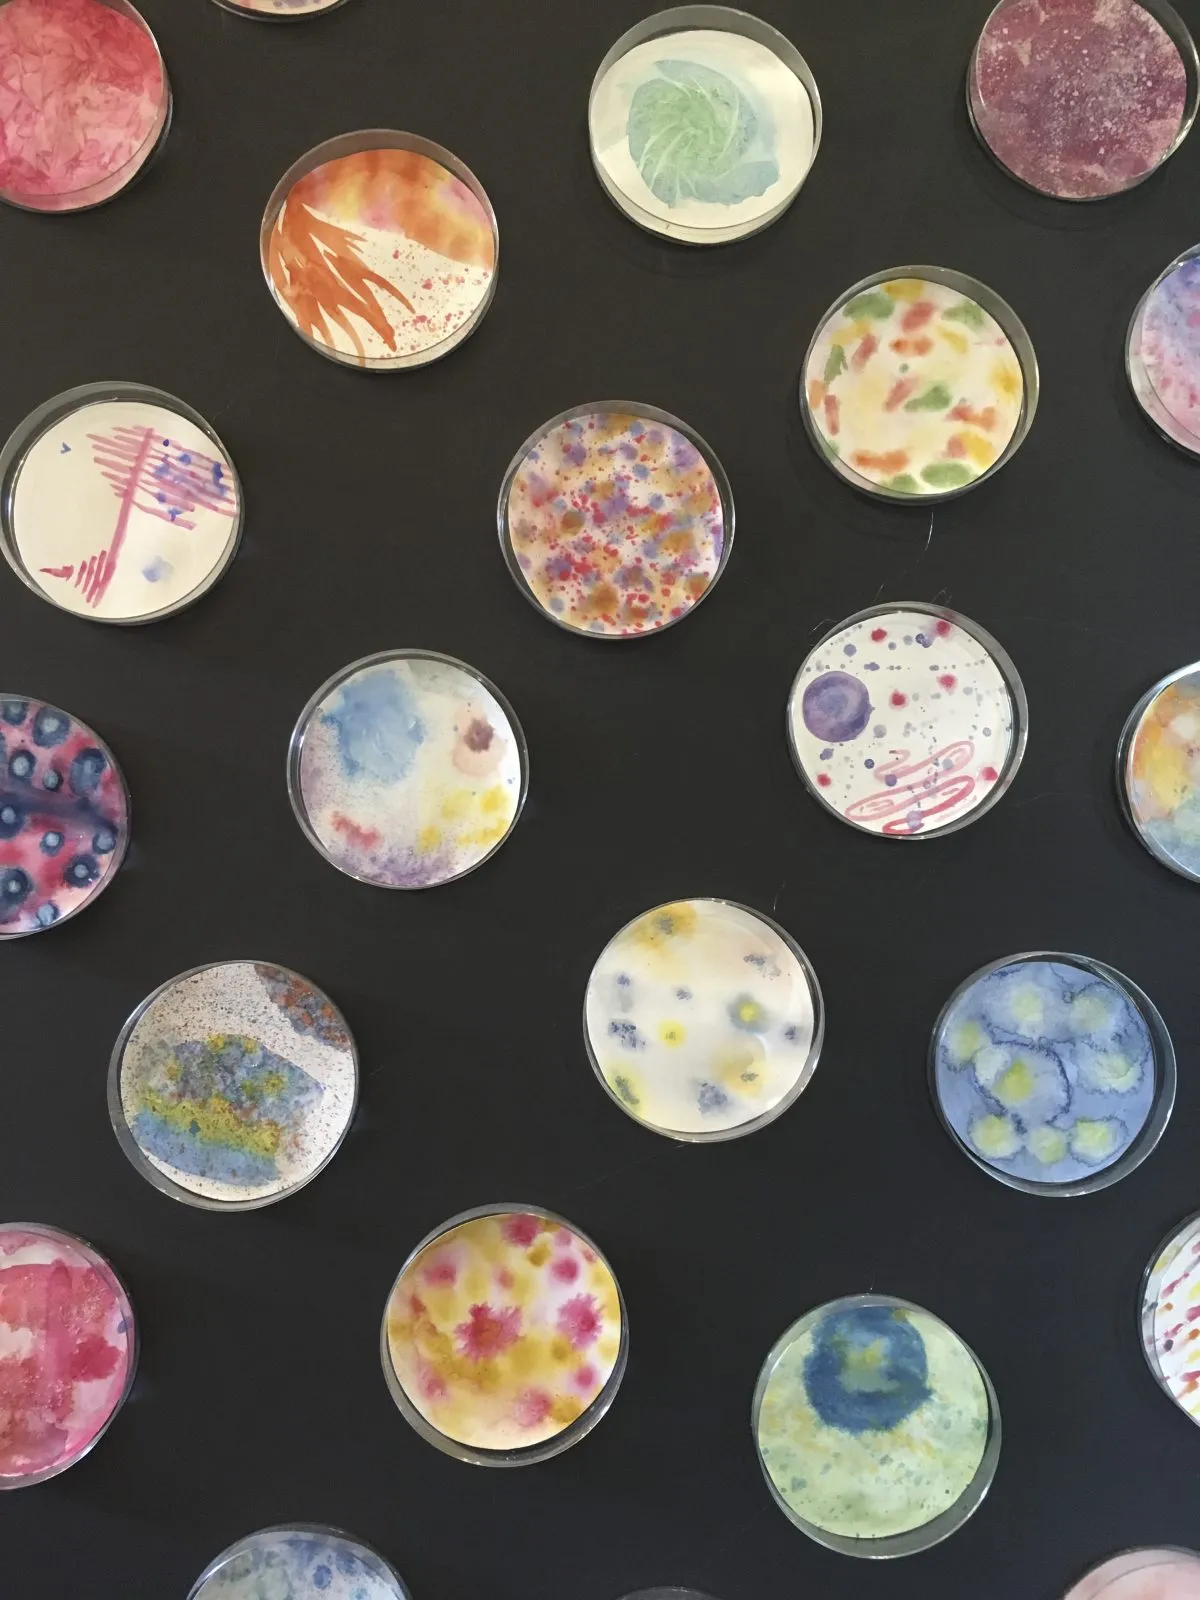

Art is for all at Beaudesert. It is the department’s aim to give pupils a strong basis in gaining experience in using a wide variety of 2D and 3D mediums, allowing all children to succeed at the subject and some to excel.
In delivering a varied curriculum it the departments hope to develop students’ passion for the subject, encourage them to take risks and to build their creative intelligence.
Pupils who have a particular talent for the subject have the option to undertake an Art Scholarship to their senior school. We have a very strong reputation for securing art scholarships and exhibitions. Extra sessions are held for these students in order for them to build up their portfolio and to their knowledge of art history. Extra art is also an option for all students as part of weekly activities.
Unusual to many prep schools, Beaudesert has a fully equipped pottery studio with a modern kiln and wheels. The children gain hands on experience of working with clay. Pottery is one of the activities on offer during the day and in the evening.
1 /
6
Scholarship Work 2023
1 /
9
Art from across the School
1 /
36
Explore more

Art and Ceramics
In delivering a varied art curriculum, the department encourages children to take risks and build their creative intelligence.
Find out more

Art and Ceramics
In delivering a varied art curriculum, the department encourages children to take risks and build their creative intelligence.
Find out more

Art and Ceramics
In delivering a varied art curriculum, the department encourages children to take risks and build their creative intelligence.
Find out more